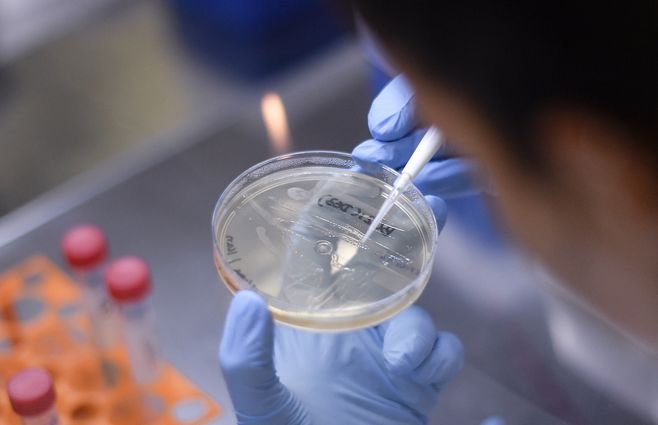
Tres fallecidos de 61, 89 y 97 por coronavirus en Montevideo, y 390 casos nuevos&nbsp;

Uruguay registró este miércoles 299 casos nuevos de Coronavirus Covid-19, en una base de 6.353 análisis procesados, lo que da una cifra total de 8.104 casos positivos acumulados desde que empezó la emergencia sanitaria.
Falleció un paciente de 82 años de coronavirus y hay 299 casos nuevos
Según el reporte del SINAE hay 2.453 personas cursando la enfermedad, y 28 de ellas se encuentran internadas en cuidados intensivos.
Del total de casos nuevos, 208 son de Montevideo, 36 de Canelones, 12 de Rivera, siete de Maldonado, seis de Rocha, seis de Salto, seis de San José, cinco de Soriano, tres de Colonia, tres de Florida, dos de Artigas, dos de Durazno y uno de Tacuarembó.
En esta jornada, el Sistema Nacional de Emergencias (SINAE) reportó otro fallecimiento por coronvavirus: se trata de un paciente de 82 años de Montevideo. La cifra de fallecidos aumentó a 87 en el territorio nacional.

Sindicato de Ancap realiza paro en La Tablada de tarde por asamblea: hasta las 13 despachan combustible
Actualmente hay 2453 personas que están cursando la enfermedad, de las cuales 28 de ellas se encuentran en cuidados intensivos. Los departamentos con casos activos al día de hoy son 18: Artigas, Canelones, Cerro Largo, Colonia, Durazno, Flores, Florida, Lavalleja, Maldonado, Montevideo, Paysandú, Río Negro, Rivera, Rocha, Salto, San José, Soriano y Tacuarembó.
Lo más visto
 video
video

Dejá tu comentario